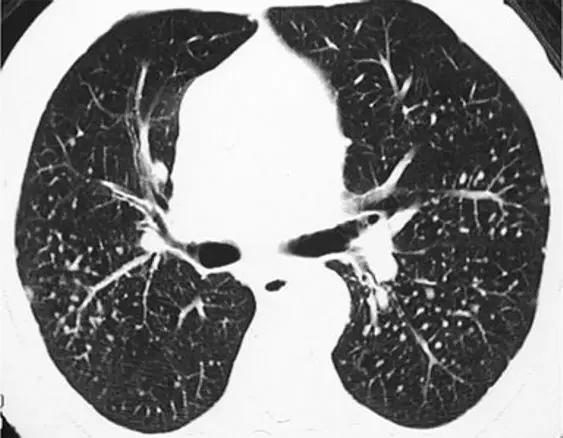
间质性肺疾病看病经验分享,分享肺腺癌临床实验的例子

来源:胸科之窗
小叶间隔增厚、结节影、网状影、磨玻璃影、铺路石样、囊状影、网状磨玻璃影,囊状与磨玻璃影、低密度影、马赛克征是间质性肺疾病在HRCT上的特征性表现。有时不同的疾病影像学非常相似,这是“异病同影”或者是某些疾病存在几种影像学表现的叠加。IPF与结缔组织病、石棉肺、晚期结节病或慢性过敏性肺炎(HP)相关的纤维化可能表现为以下肺野、胸膜下为主的网状蜂窝样改变。淋巴管肌瘤病与组织细胞增生或广泛的肺气肿可能无法区分。肺水肿和癌性淋巴管炎可能都表现为小叶间间隔增厚。过敏性肺炎和呼吸性细支气管炎伴间质性肺病(RB-ILD)都可以表现为小叶中心型结节。结节病可以呈粟粒状改变,类似粟粒性肺结核或血性播散性,而支气管结核与泛细支气管炎可能难以区分,两者均表现为树芽征。表现为磨玻璃影的非典型感染可模拟肺泡出血。在脱屑性间质性肺炎(DIP),RB-ILD和NSIP中可见伴细网状改变的磨玻璃影。闭塞性细支气管炎和小叶性肺气肿可能表现为肺部低密度影,而闭塞性细支气管炎、慢性肺栓塞和HP可能有明显的马赛克征。各种各样的表现存在于间质性肺疾病中。结合主要的HRCT表现形式和临床病史合,缩小鉴别诊断的范围。
教学要点
- 要了解与间质性肺疾病有关的不同HRCT表现形式
- 熟悉每种HRCT模式所呈现的“经典”疾病
- 讨论每种情况下不同HRCT表现形式的可能重叠和更常见的相似疾病
- 了解一些有助于区分HRCT的各种诊断模拟的线索
简 介
HRCT在综合诊断中发挥了作用,它提供了足够的信息来进行鉴别诊断,许多病例允许无创性检查明确诊断。间质性肺疾病的HRCT表现形式多种多样,每种代表不同的间质性肺疾病,具有完全不同的组织学表现和临床表现。主要的间质性HRCT模式有5种:小叶间隔增厚、网状影、结节、囊性、磨玻璃影和肺密度减低。每一种HRCT表现形式都包含许多不同的间质性肺疾病,一种疾病可能呈现许多不同的HRCT表现模式并具有许多不同的“面孔”。将HRCT表现形式与临床发现相结合对于正确诊断至关重要
HRCT 模 式
1、小叶间隔增厚
通常在HRCT的下叶的前部和下部看到很少的小叶间隔。增厚的小叶间隔表现为垂直于肺外围出现线状密度增高影,若在肺的中心部位则呈多边形结构。间隔增厚表现不同,可为光滑性、结节性及不规则性增厚。最典型的小叶间隔增厚疾病是流体静力性肺水肿。小叶间隔模式的鉴别诊断:癌性淋巴管炎,结节病和尼曼-皮克病,埃德海姆-切斯特病,囊性淋巴管扩张症和偶发性肺纤维化。

*心内膜炎继发的静水性肺水肿和二尖瓣小叶破裂。右肺的HRCT扫描显示“小叶间隔增厚模式”,其特征是右肺门旁小叶间间隔增厚。可见右胸腔积液。
癌性淋巴管炎的特征是除小叶间间隔增厚(小叶内间质,小叶间质,裂隙)以外,支气管周围血管间质的任何部分均呈结节状,少见平滑状增厚。淋巴管癌变可能是由肺或肺外肿瘤(乳腺癌,胰腺癌,胃肠道癌,前列腺癌)引起的。当由肺癌引起时,它可能是局灶性的和单侧的,而当归因于肺外肿瘤时,则通常是双边的和对称的。淋巴管癌变可能在中央或周围。分别有30%和40%的患者出现胸腔积液和淋巴结肿大。

*癌性淋巴管炎。右肺的HRCT显示出“小叶间隔增厚”模式,其特征是小叶间间隔弥漫性结节性增厚和右侧叶间裂增厚。
结节病呈小叶间隔的呈结节状或平滑增厚。当结节病表现为小叶间隔增厚时,它也可能表现出小叶内增厚,线型不透明和微淋巴结的淋巴分布,这可能会增加小叶间隔的结节性增厚。结节病通常存在上/中和中央/肺门周围优势。结节的形成(由于微结节的淋巴道分布)和纵隔淋巴结肿大(可能偶尔具有“icing sugar”钙化)的存在是结节病诊断的关键发现。

*结节病 上叶水平的HRCT显示“小叶间隔增厚”模式,其特征是小叶间间隔轻度增厚,主要出现在肺的外围和胸膜后区域。还注意到右钙化气管旁淋巴结。
2.网状影
在HRCT上,网状图案的特征是网格的无数杂*交乱**错阴影。网状结构的成分可能是以下的全部或部分:小叶间隔增厚,小叶间质增厚,蜂窝壁囊肿,支气管周围血管间质增厚和牵引性支气管扩张/支气管扩张。典型的疾病是IPF。IPF表现为下肺野、后基底段、胸膜下为主,显著的网状蜂窝样改变。IPF和网状结构的主要鉴别疾病是NSIP,石棉肺,慢性过敏性肺炎,类风湿性关节炎,DIP和晚期结节病。

*特发性肺纤维化。下叶水平的HRCT表现为胸膜下“网状结构”,其特征是小叶间间隔增厚,小叶间质增厚,牵拉性支气管扩张和支气管扩张以及最小程度的蜂窝状。
NSIP的特征是下肺野、胸膜下为主的轻微网状状改变、毛玻璃影,几乎没有蜂窝样改变,即便有也在重叠区域。NSIP与IPF不同的是以毛玻璃改变为主,几乎没有蜂窝样改变。

*非特异性间质性肺炎。下叶水平的HRCT表现出“网状模式”,其特征是存在支气管周围血管间质增厚以及牵引性支气管扩张和支气管扩张。
石棉肺也以网状模式为主,因此可能模仿IPF。其特征是在早期存在胸膜下网状结构和胸膜下点状混浊。可能存在磨玻璃影的区域,且发现主要在后段和基底段。在后期,蜂窝样改变是很常见的发现。与IPF鉴别诊断的线索可能是存在胸膜斑、弥漫性胸膜增厚、胸膜下曲线或实质带。

*石棉肺。 HRCT下叶水平扫描显示“网状模式”,其特征是存在胸膜下牵引支气管扩张和支气管扩张,支气管周围血管间质和小叶间隔的蜂窝状和增厚。钙化的胸膜和胸膜斑(白色和黑色箭头)的存在为诊断石棉肺提供了明确的线索。
慢性过敏性肺炎(HP)表现为斑片状,周围或支气管血管网状,并可能与IPF类似。它的特征是存在牵引性支气管扩张和细支气管扩张以及最小程度的蜂窝状改变。毛玻璃影和小叶中心型微结节可能并存。在将慢性HP与特发性IPF和NSIP区分中最有用的CT检查结果是:肺密度减低的小叶区和多血管区的存在,中心小叶结节的存在。

*慢性HP 下叶水平的HRCT表现为粗大的“网状图案”,伴有牵张性支气管扩张和支气管扩张,小叶内和支气管血管间质增厚以及磨玻璃样改变。小叶密度减低为慢性超敏性肺炎的诊断提供了“关键”证据。
类风湿关节炎(RA)中最常见的间质性肺病的组织学类型是UIP和NSIP,因此RA可能呈网状模式,模仿IPF或NSIP。HRCT表现为胸膜下基底网状组织伴轻度蜂窝状。

*类风湿关节炎伴有肺纤维化。下叶水平的HRCT表现为粗糙的“网状图案”,由牵拉性支气管扩张和支气管扩张,小叶内和支气管血管间质增厚,毛玻璃样混浊和蜂窝状组成。
脱屑性间质性肺炎(DIP)可能很少模仿IPF,因为它可能伴有胸膜下基底网状组织。通常不存在蜂窝,磨玻璃改变是常见的发现,肺气肿和肺囊肿的存在可能有助于鉴别诊断。

晚期结节病表现为类似IPF的纯网状模式,特征是小叶间隔增厚,小叶内线性混浊,牵引性支气管扩张和蜂窝状结节。支持结节病诊断的主要发现是中上肺为主,支气管血管束周围结节性增厚和对称淋巴结肿大,有时伴有钙化。

*晚期结节病。下叶水平的HRCT表现为粗大的“网状图案”,肺结构变形,胸膜下牵引支气管扩张和支气管扩张,支气管周围血管间质增厚和蜂窝状改变。
3、磨玻璃影模式
HRCT上的磨玻璃样改变被定义为不透明的薄雾影增加,并保留了支气管和血管标记。经典疾病:亚急性过敏性肺炎(HP),其特征是磨玻璃样混浊的对称斑片或弥散性双侧区域,伴有边界义不清的小叶中心型结节。有助于将亚急性HP与其他相似疾病分开的特征是,在吸气图像和气管呼气图像上,小叶区域的衰减和多血管影。磨玻璃样的最常见的鉴别疾病是呼吸性毛细支气管炎相关的间质性肺病(RB-ILD)、脱屑性间质性肺炎(DIP)和肺囊虫性肺炎。

*亚急性过敏性肺炎。 HRCT显示“磨玻璃样”改变,有少量小叶结构,没有纤维化改变
RB-ILD可表现为中度到广泛性的双侧磨玻璃影,边界不清的小叶中心型结节,支气管壁增厚。有时,在肺基部可能会出现轻微的网状结构。区分RBILD和亚急性HP的线索是RB-ILD存在上叶轻度肺气肿,HP吸烟者存在吸烟习惯的改变。

*RB-ILD 上叶水平的HRCT显示弥散的“毛玻璃样”,小叶透亮区代表伴随的小叶肺气肿。
脱屑性间质性肺炎(DIP)通常表现为弥漫性磨玻璃样混浊,并以胸膜下和肺下占优势为主。在一半的病例中可以看到轻度的胸膜下网状结构。蜂窝状和牵引性支气管扩张最少。在DIP中也见到了小叶性肺气肿,与RB-ILD类似,但在DIP中更可能出现下肺轻度网状改变。吸烟史应伴随DIP的诊断,因为DIP几乎总是与吸烟有关。
耶氏肺孢子菌肺炎(PJP)通常表现为广泛的磨玻璃样改变,其可能为斑块状或弥散性,以中央,肺门和上叶为主。伴随的发现可能是小叶间裂的增厚,而很少出现“铺路石”的现象。有别于HP的发现可能是上叶囊肿的存在和相关的“铺路石”样改变。模式。免疫抑制(尤其是艾滋病)的病史有助于其诊断。

*PJP 下叶水平的HRCT表现为“毛玻璃样”的地理区域,没有肺纤维化或肺囊肿的改变 。
4、铺路石征
HRCT上的“铺路石”的特征是存在小叶间隔和小叶内线增厚,并叠加在磨玻璃不透明的背景上,类似于形状不规则的铺路石。
经典疾病:肺泡蛋白沉着症(PAP),通常表现为双肺磨玻璃体浑浊影,伴有小叶间隔光滑增厚及地图样分布的平滑间隔增厚,主要位于肺门周围和下肺野。“铺路石”模式最常鉴别疾病包括PJP、外源性脂质肺炎、结节病、弥漫性肺泡出血、病毒和机会性感染以及浸润性黏液腺癌。

肺泡蛋白沉着症
脂质性肺炎 就HRCT而言,有利于脂质性肺炎而非PAP诊断的特征是存在不明确的小叶小结节和实变影并存,支气管活检、支气管肺泡灌洗和脂质类物质吸入史通常可诊断为ELP。
结节病可能很少以“铺路石”为主要特征,但由于结节病是间质性肺病的“最佳模仿者”,因此应牢记结节病这种罕见但重要的“面孔”。

*结节病。下叶水平的HRCT在肺的胸膜下区域表现出“铺路石”,伴有平滑且结节状的小叶间间隔增厚。注意分裂处的“串珠”外观,尤其是在左侧
免疫功能低下患者的病毒和机会感染(腺病毒、单纯疱疹、流感病毒、巨细胞病毒、呼吸道合胞病毒和弓形体病)通常表现为“铺路石”。在这些情况下的主要发现是根据临床病史。
肺腺癌的许多面孔之一是“铺路石”,其中磨玻璃衰减反映出低密度肺泡内物质(糖蛋白)和重叠的小叶间隔增厚,这是由炎性肿瘤细胞的间质浸润引起的。浸润性黏液腺癌诊断的关键发现是后续影像学检查显示出不吸收的实变影或磨玻璃样改变。
5、磨玻璃影-网状影混杂模式
有时,在肺部同一区域中可能同时存在磨玻璃样影和网状影共存,这种组合几乎等同于不可逆的纤维化。典型疾病:是非特异性间质性肺炎(NSIP)。表现为磨玻璃影改变为主、轻度网状改变。鉴别疾病:硬皮病、特发性肺纤维化(IPF)和脱屑性间质性肺炎(DIP)。
硬皮病的肺部侵袭类似于NSIP,因为它是最常见的组织学类型的纤维化。有利于硬皮病的主要发现是食管扩张和肺动脉扩张。

*硬皮病。下叶水平的HRCT表现为混合的“磨玻璃样和网状样”,其特征是磨玻璃样改变和牵引性支气管扩张。请注意5 mm胸膜下不受累,这是硬皮病最常见的组织学类型NSIP的特征相关性肺纤维化。
特发性肺纤维化(IPF)有时可能与NSIP难以区分,HRCT在区分IPF和NSIP方面的特异性范围为63%至70%。有利于IPF的鉴别诊断是呈现显著的网状蜂窝样改变,少许毛玻璃改变。

*IPF HRCT在肺底水平上表现出混合的“磨玻璃样和网状图案”,其特征是磨玻璃样改变的区域内可见牵引性支气管扩张和支气管扩张。少许蜂窝样改变。
单纯的脱皮性间质性肺炎(DIP)是罕见的,但其最常见的模式是磨玻璃样改变伴有轻度网状改变,能类似于NSIP,通常没有蜂窝状改变(图22)。可能有助于鉴别诊断的细微CT特征是存在可能代表肺气肿的小微囊肿(因为患者几乎总是吸烟者),支气管扩张或肺泡管扩张(无明显的蜂窝状纤维化)。

*DIP 患者HRCT的下叶水平显示出混合的“磨玻璃样改变伴轻度网状结构”。无蜂窝样改变
6、结节影
HRCT上的结节性形态的特征是存在许多圆形密度影,直径范围从2 mm到1 cm,微结节的直径小于3 mm [38]。除临床情况和辅助检查结果外,鉴别诊断主要基于解剖分布的三种不同模式:淋巴分布、随机分布和小叶分布。淋巴分布的特征是沿支气管周围血管间质,小叶间隔和胸膜下区域存在结节。随机分布显示结节,没有任何特定的站点优势。小叶小结节距胸膜表面,小叶间裂或小叶间隔几毫米。中心小叶分布进一步分为有和没有树芽状分布的结节。
6.1淋巴管分布结节
按淋巴管分布的结节典型疾病是结节病。结节主要位于肺门附近及中上肺野。

*结节病 上叶水平的HRCT表现为“无树芽征的结节状结节”,其特征是小叶间隔,裂隙,支气管血管束和胸膜周围存在淋巴小结节。
矽肺病的是结节病的模仿者,通常表现为淋巴管和小叶中心尖锐的微结节,范围从2mm到5 mm。结节的定义清晰且密度均匀,上叶和后段为主。支持矽肺病诊断的明显发现是微结节的聚结,淋巴结的蛋壳钙化形成的团块(罕见,仅占结节的5%)病例和胸膜下假性斑块的形成,同样是基于胸膜下微结节的合并。在大多数情况下,有接触史。
*矽肺病。上叶水平的CT表现为“无树芽征的结节状影”,特征是明确定义的均质小叶结节,主要位于上叶和后段。
尘肺病和硅肺病是吸入不同无机粉尘引起的两个不同的疾病,通常难以区分。有时一个独特的特征是,与矽肺病相比,CWP的微结节往往不那么清晰,颗粒密度更高。

*煤矿工人尘肺病。上叶水平的HRCT表现出“结节状影”,其特征是定义不明确的小叶状结节,大小不等,主要位于上叶和后段
淋巴管结节可能伴有淋巴管癌变和淋巴增生性疾病(例如淋巴瘤),但这通常不构成其主要的HRCT模式,并伴有其他发现,如间隔增厚(在前者)和大实质性结节或肿块(在后者)有助于鉴别诊断
6.2随机分布结节
粟粒性肺结核是整个两个肺组织中随机分布的微小结节的典型例子,直径为1mm至3 mm。微结节直径均匀,在肺内分布均匀。在影像学上可能无法区分感染性疾病和粟粒性肿瘤的肿瘤性原因。但是,粟粒性结核可能更常伴有淋巴结病和胸腔积液。

*粟粒性结核。上叶水平的HRCT表现出“粟粒状结节型”,其特征是在大小大致相同的肺内散布且对称分布的随机微结节。
随机分布的结节型最常见的鉴别疾病是粟粒转移性疾病,以及其他粟粒性感染,例如粟粒念珠菌病。与粟粒性结核不同,结节大小可能可变(最大1cm),均匀或不均匀。它们通常位于肺的外部三分之一,多位于较低区域,并且符合“结节过多以至无法计数”的标准。

*粟粒性转移性疾病。上叶水平的HRCT显示“乳头状结节型”,其特征是散布在整个肺中的随机和淋巴小结节,其大小与粟粒性肺结核结节相比变化更大。
6.3有树芽征表现的小叶中心型分布结节
表示类似于发芽树的中心叶分支结构。该模式反映了细支气管内和细支气管周围疾病的形态,包括粘液样、炎症、纤维化以及偶发的血管内疾病,例如赘生物。典型疾病:细支气管炎,其特征是在病程后期,呈“树状”花纹的弥漫性双侧分布,具有较低的肺为主,伴相关细支气管扩张和支气管扩张。

*细支气管炎。下叶和中叶水平的HRCT表现为“结节状,树芽征”,遍布整个肺
鉴别疾病:结核的支气管播散,非典型分枝杆菌感染和转移性肿瘤栓子。
结核的支气管播散是这种HRCT模式的著名代表,可以根据病灶和病灶的不同与全细支气管炎区别开来。

*结核。下叶和中叶水平的HRCT主要表现在右下叶“结节状且有芽状”,与结核病的支气管内扩散相一致。
非典型分枝杆菌感染 有利于诊断非典型分枝杆菌感染的主要发现是多叶,圆柱形支气管扩张症的存在,在中叶和舌状舌中往往更严重,以及受影响患者的特征:老年妇女。可能引起的其他较不常见的感染是肺念珠菌病。支气管浸润曲霉病和CMV肺炎。

*一名老年妇女的非典型分枝杆菌感染。 HRCT在中叶,舌叶和下叶上段的水平处显示出“结节状,树芽征”,伴有中叶轻度圆柱形支气管扩张和和粘液堵塞。
6.4不明确的小叶中心型分布结节(不伴树芽征)
这种模式的特征是存在从胸膜表面,裂隙或小叶间隔几毫米处出现的磨砂玻璃衰减的定义不明确的小叶小结节。经典疾病:亚急性过敏性肺炎,通常以这种模式为主要模式。鉴别疾病:呼吸性细支气管炎伴间质性肺病(RB-ILD)、隐源性机化性肺炎、淋巴细胞性间质性肺炎和滤泡性细支气管炎。
7、网状-结节影
特征是网状和微结节同时存在。微结节可能位于网状改变的中心(小叶微结节),也可能位于代表中隔或支气管血管微结节的线性模糊影上。经典疾病:结节病。鉴别疾病:铍中毒。即使从组织学基础上也无法与结节病区分开。

*结节病。上叶水平的HRCT表现出“网结节状模式”,其特征是小叶间隔膜和支气管血管束增厚,淋巴和周壁微结节以及结构畸变。
8、囊性病变
囊性模式由界限分明,圆形和外接空气的实质组成,有界限分明的壁和与正常肺。
经典疾病:淋巴管平滑肌肌瘤病(LAM),其特征是通常存在圆形的薄壁肺囊肿,没有在局部明显的特点,分布广泛,包括肋骨角和肺底。 LAM可能伴有胸水表现为胸膜胸腔积液。鉴别诊断是随机分布的囊肿,临床病史表现几乎只影响着育龄妇女。鉴别疾病:是肺组织细胞增生症、淋巴细胞性间质性肺炎(LIP)和小叶性肺气肿。

*LAM。上叶水平的HRCT表现出“囊性模式”,其特征是位于肺实质和隔中的许多大小不等的薄壁“真”囊腔的存在。
肺组织细胞增生症在处于纯囊性期(纯结节性和结节性-囊性期之后的第三期)时模拟LAM。它的特征是存在薄壁和厚壁的囊、形状呈异形,类似于苜蓿叶。囊肿具有特征性以上部和中部肺区分布为主。

*组织细胞增多症。上叶水平的HRCT揭示了一种“囊肿型”,其特征是许多薄或厚的“真”囊肿,形状奇异,大小不一。在右胸膜腔中发现引流导管以治疗气胸,这是这位27岁重度吸烟患者。
淋巴细胞性间质性肺炎 (LIP)可能很少以弥散性肺囊肿为主要HRCT模式(图37)。鉴别诊断中支持LIP的主要发现是与其他辅助发现相关,例如磨玻璃样不透明的弥散性或斑片状区域,不明确的小叶小结节和支气管血管束增厚。此外,引起某种程度的免疫抑制的原发性疾病的临床病史(如干燥病,艾滋病,自身免疫性疾病,蛋白异常)为LIP提供了强有力的线索。

*淋巴细胞性间质性肺炎。上叶水平的HRCT揭示了一种“囊性模式”,其特征是极少的薄壁“真”囊肿,可能具有圆形或更多的分叶形状。免疫抑制的历史(艾滋病,干燥综合征,自身免疫性疾病,蛋白异常)有利于LIP的特异性诊断
小叶中心性肺气肿虽然不存在“真正的”囊,但有时可能会模仿由囊性表现的其他间质性肺疾病。

*中央小叶气肿。HRCT显示在大多数情况下,放射状的小叶中心区没有可辨认的壁(除了小叶间间隔增厚的区域),并且有一个中心白点(在放射线的中心)代表中心小叶动脉(白色箭头) )。中央小叶肺气肿偶发间质性疾病,表现为“真正的囊性病变” 。
9、囊性病变伴磨玻璃影
特征是同时出现了两种HRCT模式。经典疾病:PJP。鉴别疾病:淋巴细胞性间质性肺炎、亚急性过敏性肺炎和脱屑性间质性肺炎。
10、马赛克征
这种模式的特征是增加和减低的密度混杂拼凑,这可能代表(1)分布不均的间质性疾病,(2)闭塞性小气道疾病和(3)闭塞性小血管疾病 。经典疾病:闭塞性细支气管炎(OB)。

*囊性纤维化患者的闭塞性细支气管炎。在(a)吸气和(b)呼气时在隆突水平进行HRCT在呼气时显示“马赛克衰减模式”,其次空气滞留征(b),在吸气时未显示(a)
鉴别疾病:慢性血栓栓塞性肺动脉高压可能由于斑片状的血管性低氧血症而表现出马赛克征。亚急性超敏性肺炎也可能表现出马赛克衰减模式,既表现为“间质性”病因,表现为衰减增加的区域(磨玻璃影不透明),又表现为“小气道疾病”病因,表现为衰减减少的区域,可能加剧。呼吸性细支气管炎也可能是这种模式。
结 论
HRCT间质性肺疾病的评估基于经典影像学模式的诊断方法,应努力为每个表现为“肺间质性疾病”分配主要的HRCT模式。每种HRCT模式中都有多种相似或需要鉴别疾病,同病异影或异影同病现象非常普遍。此外,我们应该记住,没有HRCT模式可以提供特定的病因诊断。为了达到正确的诊断,应该通过识别任何特定且独特的影像学线索来接近主要的HRCT模式,并尝试通过将HRCT结果与临床和实验室检查结果相结合。
【版权声明】本平台属公益学习平台,转载系出于传递更多学习信息之目的,且已标明作者和出处,如不希望被传播的老师可与我们联系删除